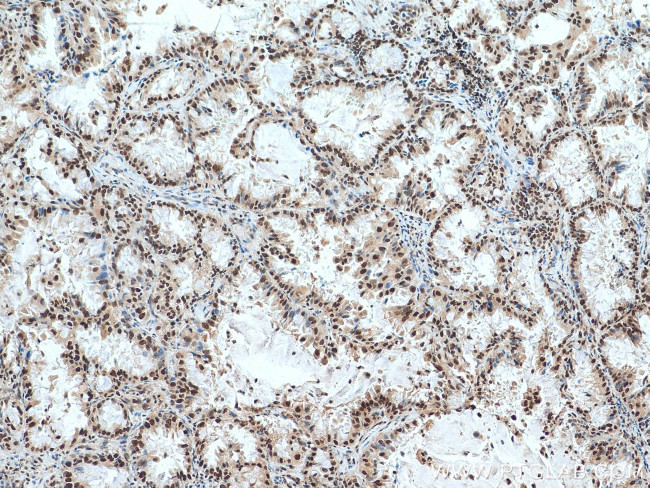
ACTL6A Antibody in Immunohistochemistry (Paraffin) (IHC (P))

Search
Proteintech
ACTL6A Polyclonal Antibody
{{$productOrderCtrl.translations['antibody.pdp.commerceCard.promotion.promotions']}}
{{$productOrderCtrl.translations['antibody.pdp.commerceCard.promotion.viewpromo']}}
{{$productOrderCtrl.translations['antibody.pdp.commerceCard.promotion.promocode']}}: {{promo.promoCode}} {{promo.promoTitle}} {{promo.promoDescription}}. {{$productOrderCtrl.translations['antibody.pdp.commerceCard.promotion.learnmore']}}







Please note: We are reviewing Western blot images included in the antibody testing data in our catalog, including those provided by third parties. Unless expressly labeled or annotated as “raw-unedited”, Western blot images included in the antibody testing data in our catalog may have been edited, optimized or otherwise adjusted for presentation.
产品信息
10341-1-AP
种属反应
已发表种属
宿主/亚型
分类
类型
抗原
偶联物
形式
浓度
规格
纯化类型
保存液
内含物
保存条件
运输条件
产品详细信息
Immunogen sequence: YTVRAGYAG EDCPKVDFPT AIGMVVERDD GSTLMEIDGD KGKQGGPTYY IDTNALRVPR ENMEAISPLK NGMVEDWDSF QAILDHTYKM HVKSEASLHP VLMSEAPWNT RAKREKLTEL MFEHYNIPAF FLCKTAVLTA FANGRSTGLI LDSGATHTTA IPVHDGYVLQ QGIVKSPLAG DFITMQCREL FQEMNIELVP PYMIASKEAV REGSPANWKR KEKLPQVTRS WHNYMCNCVI QDFQASVLQV SDSTYDEQVA AQMPTVH (21-286 aa encoded by BC001391)
靶标信息
BAF53A is a family member of actin-related proteins (ARPs), which share significant amino acid sequence identity to conventional actins. Both actins and ARPs have an actin fold, which is an ATP-binding cleft, as a common feature. The ARPs are involved in diverse cellular processes, including vesicular transport, spindle orientation, nuclear migration and chromatin remodeling. This gene encodes a 53 kDa subunit protein of the BAF (BRG1/brm-associated factor) complex in mammals, which is functionally related to SWI/SNF complex in S. cerevisiae and Drosophila; the latter is thought to facilitate transcriptional activation of specific genes by antagonizing chromatin-mediated transcriptional repression. Together with beta-actin, it is required for maximal ATPase activity of BRG1, and for the association of the BAF complex with chromatin/matrix. Three transcript variants that encode two different protein isoforms have been described.
仅用于科研。不用于诊断过程。未经明确授权不得转售。
生物信息学
蛋白别名: 53 kDa BRG1-associated factor A; actin-like 6; actin-like 6B; Actin-like protein 6A; Actin-related protein Baf53a; ACTL6B; ArpNbeta; BAF53A; BAF53B; BRG1-associated factor 53A; BRG1/brm-associated factor 53A; hArpN alpha; INO80 complex subunit K; MGC5382; MGC5382 Arp4
基因别名: 2810432C06Rik; Actl6; ACTL6A; AI851094; ARP4; BAF53; BAF53A; C79802; INO80K; RGD1307747
UniProt ID: (Mouse) Q9Z2N8
Entrez Gene ID: (Mouse) 56456, (Rat) 361925